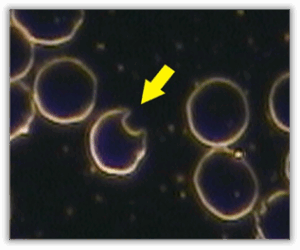
Keratocytes

You must be logged in to record observations.
Short Description
Keratocytes are red blood cells that appear fragmented or irregularly shaped, often showing sharp angles, horn-like projections, or helmet-style contours. Rather than maintaining a smooth, rounded outline, these cells look as though part of the membrane has been altered or reshaped during circulation.
This pattern reflects mechanical or environmental stress acting on red blood cells as they move through the bloodstream. When red blood cells encounter less favourable circulating conditions, their membranes may deform, resulting in these distinctive shapes.
The presence of keratocytes highlights a blood terrain where red blood cells may be under increased physical or environmental strain, affecting their resilience and ability to circulate efficiently.
Appearance
- Also known as ‘helmet cells’ or ‘bite cells’. Keratocytes are RBCs with one or more horn-like projections. They often appear as though a bite has been taken from one side of the RBC membrane. This morphology arises due to oxidative stress or mechanical trauma that causes the RBC membrane to rupture partially. They can be distinguished from acanthocytes and echinocytes by their irregular, ‘bitten’ shape rather than spiked projections.
Pleomorphic Perspective
- Keratocytes are associated with dioekothetcits – small, rod-like growth forms observed under darkfield microscopy. They are seen emerging from the RBCs, representing an upward stage in the endobiontic cycle. Their presence suggests dysbiosis and toxic terrain. When viewed in a saline test, these rods continue to move independently, confirming their pleomorphic nature and vitality.
Medical Perspective
- Keratocytes, also termed ‘helmet cells’, occur when RBCs rupture due to mechanical shearing or oxidative damage. They are observed in microangiopathic haemolytic anaemias, disseminated intravascular coagulation (DIC), pulmonary emboli, myeloid metaplasia, and after vascular prosthesis. They also occur in liver disease, glomerulonephritis, haemangiosarcoma, lymphosarcoma, and other anaemias involving fragmentation.
Relevance
- Keratocytes are not normally observed in healthy blood samples. Their presence is significant and indicates RBC membrane fragility or oxidative injury.
Implications
- This anomaly is most often caused by intracellular oxidative stress. The oxidative damage to the RBC haemoglobin leads to the black spots observed in advanced poikilocytes. The irregularity of the RBC membrane then leads to macrophage attack in the spleen, where the damaged portion of the cell is removed, preserving the rest of the cell.
- The mechanism of keratocyte formation can also be the same as with schistocytes: mechanical trauma to the RBCs as they pass through intravascular fibrin strands.
- Splenic dysfunction, Post-Splenectomy (surgical removal of the spleen). Keratocytes are observed in these cases because macrophages (WBCs) in the spleen would normally remove these cells from the circulation.
Associated Symptoms
- Fatigue and weakness.
- Dizziness.
- Poor circulation.
- Possible hypertension.
- Signs of haemolysis in advanced stages.
Interventions
Detox Protocol:
- Hepaton + Lymphlux + Nephrocil + HumiCaps + detox diet.
Supplements:
- Omega-3 supplement (1000–2000 EPA daily).
- Vitamin E: start with 400 mg daily, gradually increase to 800 mg.
- Buffered Vitamin C (2500 mg).
- Co-enzyme Q10 (Ubiquinol Co-Q10): 50 mg 2× daily.
- Selenium (200 µg), Zinc (25 mg), Beta-carotene (10,000 IU), Glutathione, and Super Oxide Dismutase
- Trace minerals: Bio-Ionic Minerals
Working with
- Keratocytes indicate oxidative damage and microvascular stress. When present, focus on detoxification and antioxidant support. If there is suspicion of mechanical haemolysis or vascular pathology, clinical investigations should be pursued. Assess for contributing factors such as liver dysfunction, microangiopathy, or drug-induced oxidative stress.
General Guidelines
- Increase water intake: Weight (kg) ÷ 8 × 0.25 = litres/day.
- Increase intake of fibre-rich carbohydrates and raw polyunsaturated fats.
- Include raw vegetable juices, sprouts, greens, and antioxidant-rich superfoods.
- Avoid saturated fats, refined carbohydrates, and enzyme-deficient foods.
- Stop smoking.
- Avoid alcohol, caffeine, sugar, and unnecessary medication.
- Reduce exposure to environmental toxins and heavy metals.
Functional Systems Influenced
Hematological
Keratocytes reflect focal disruption of red blood cell membrane integrity. This directly affects red blood cell structure and highlights increased mechanical or environmental stress acting on circulating cells.
Circulation & Hydration
Red blood cells must deform repeatedly as they pass through small vessels. When circulation conditions place greater shear or frictional stress on cells, localized membrane damage may occur, contributing to the keratocyte appearance.
Oxidative & Antioxidant Balance
Red blood cell membranes are sensitive to oxidative influences. Reduced antioxidant protection can weaken membrane resilience, making cells more susceptible to focal damage rather than uniform shape change.
Cardiovascular
The forces generated within circulation influence how red blood cells are mechanically challenged. Keratocytes can reflect increased circulatory strain rather than a primary structural defect in the cells themselves.
Commonly Associated Terrain Imbalances
Acidic terrain
Shifts toward a more acidic internal environment can influence red blood cell membrane stability, increasing susceptibility to localized membrane disruption during circulation.
Dehydration / plasma viscosity ↑
Reduced plasma fluidity can increase friction and shear forces within the bloodstream, placing greater mechanical stress on red blood cells and contributing to focal membrane damage.
Low antioxidant reserve
When antioxidant protection is limited, red blood cell membranes may be less resilient to everyday environmental and mechanical stressors, allowing localized damage to occur.
Oxidative stress ↑
Oxidative influences can weaken membrane structure, increasing vulnerability to focal injury rather than uniform shape change.
Protein intake / albumin low
Adequate plasma protein balance supports membrane stability and buffering against mechanical stress. Reduced albumin availability may contribute to increased membrane fragility.
Supportive Focus & Awareness
-
Awareness of factors that influence red blood cell membrane resilience and structural integrity
-
Awareness of hydration and fluid balance as they relate to mechanical stress within circulation
-
Awareness of oxidative balance and everyday influences on cellular stability
-
Awareness of circulation quality and the physical demands placed on red blood cells as they move through small vessels
-
Awareness of overall energy levels, stamina, and recovery during periods of physical or metabolic demand
Commonly Reported Experiences
- Some individuals whose blood patterns include keratocytes report general fatigue, weakness, or reduced stamina, particularly during periods of physical or mental demand. Dizziness or light-headedness is also sometimes mentioned.
- Others describe sensations related to circulation, such as feeling cold in the hands or feet, or a sense that circulation is less efficient overall.
- In some cases, people report experiences that prompt broader awareness of blood flow or red blood cell health, particularly when similar patterns are observed consistently over time. These observations do not indicate a diagnosis but may encourage attentiveness to overall cardiovascular and blood-related wellbeing.
These experiences are non-specific and can be influenced by many factors, including hydration, stress, activity levels, and overall health. Their presence does not confirm any condition and should always be considered in the wider context of individual circumstances and other observations.
Systems / Body Functions
Cardiovascular, Circulation & Hydration, Hematological, Oxidative & Antioxidant Balance
Imbalances
Acidic terrain, Dehydration / plasma viscosity ↑, Low antioxidant reserve, Oxidative stress ↑, Protein intake/albumin low
Keratocytes are red blood cells that appear fragmented or irregularly shaped, often showing sharp angles, horn-like projections, or helmet-style contours. Rather than maintaining a smooth, rounded outline, these cells look as though part of the membrane has been altered or reshaped during circulation.
This pattern reflects mechanical or environmental stress acting on red blood cells as they move through the bloodstream. When red blood cells encounter less favourable circulating conditions, their membranes may deform, resulting in these distinctive shapes.
The presence of keratocytes highlights a blood terrain where red blood cells may be under increased physical or environmental strain, affecting their resilience and ability to circulate efficiently.
Keratocytes are associated with dioekothetcits – small, rod-like growth forms observed under darkfield microscopy. They are seen emerging from the RBCs, representing an upward stage in the endobiontic cycle. Their presence suggests dysbiosis and toxic terrain. When viewed in a saline test, these rods continue to move independently, confirming their pleomorphic nature and vitality.